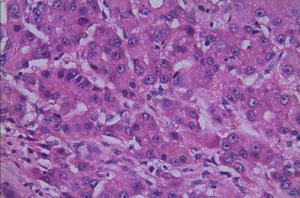
肝細胞性肝癌 肝細胞性肝癌

解釋
肝細胞性肝癌:癌細胞排列形成實性團塊狀,周圍富有擴張的血竇。癌細胞境界不清,大小較一致,漿寬。核單個,類圓形,異形性不明顯。核分裂象少見。
肝細胞癌(HCC)是肝癌的主要組織學亞型,占原發性肝癌的90%,是全世界癌症相關死亡率的第三大常見原因。遺傳、表觀遺傳改變、慢性B型肝炎、C型肝炎病毒感染、黃麴黴毒素暴露、吸菸、肥胖和糖尿病等是肝癌的主要危險因素。肝癌預後差的原因是復發率和轉移率高。目前,移植是治療肝癌最有效的方法,但在移植過程中,腫瘤復發率和轉移率較高。無論是由於腫瘤負擔還是肝功能不好,70%以上的晚期患者不適合移植。